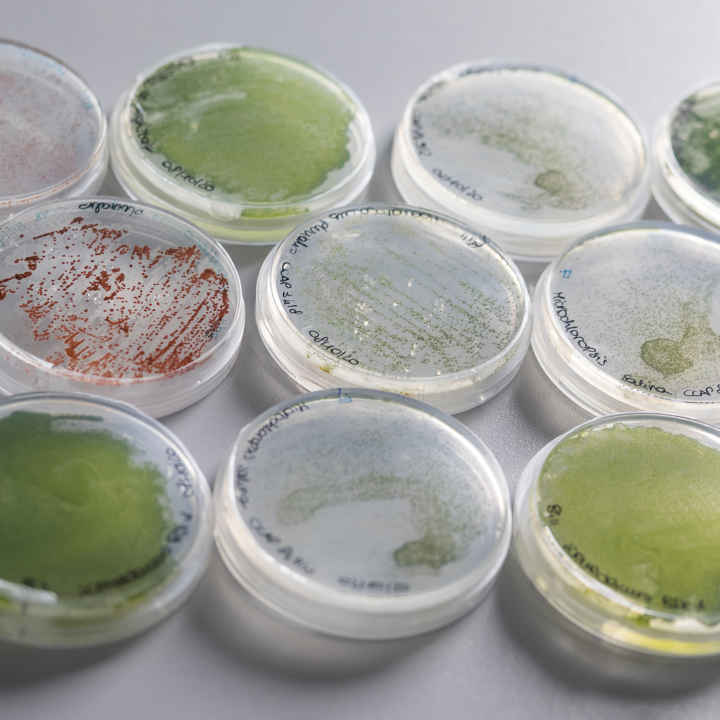
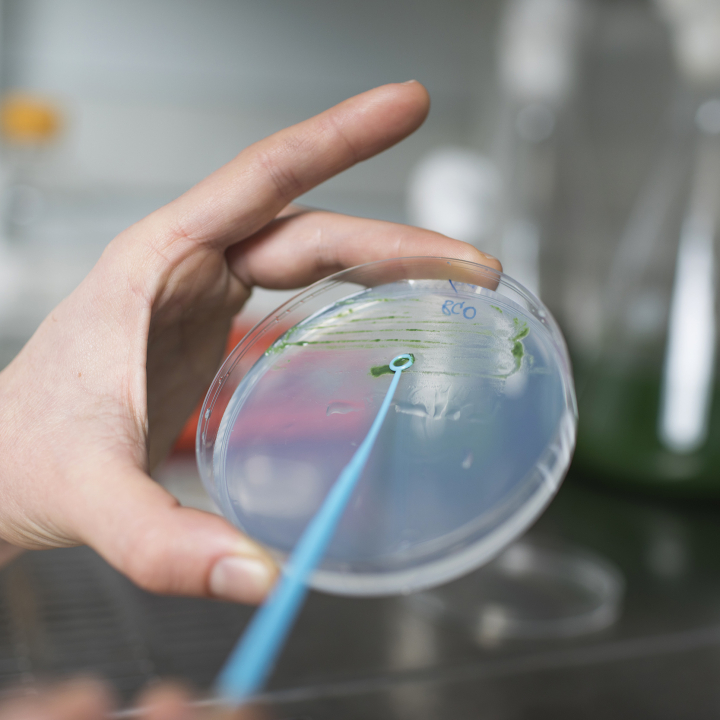

Valore nutrizionale e funzionale
Le microalghe combinano nutrizione e funzionalità biologica.Sono ricche di proteine, vitamine, minerali e acidi grassi polinsaturi, e contengono carotenoidi e composti bioattivi naturali con proprietà antiossidanti, antinfiammatorie e immunomodulanti.
Una fonte sicura, versatile e completamente naturale.

Sostenibili per natura
Crescono con basso consumo di risorse.Un processo naturale che unisce biotecnologia, efficienza e tutela ambientale.

Versatility and customization
La nostra Algae Bank raccoglie ceppi selezionati per applicazioni in agricoltura, alimentazione, cosmetica e nutrizione animale.Ogni ceppo offre funzioni specifiche e risultati mirati.
In BioSyntex, la ricerca scientifica si traduce in prodotti reali — dal laboratorio al mercato.